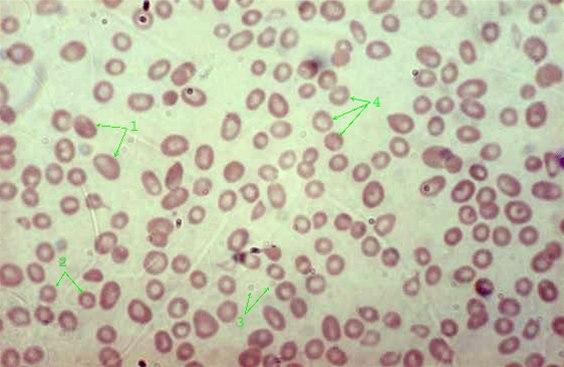

Folatmangel
Folatmangel hos gravide øker risikoen for ryggmargsbrokk hos fosteret. Generelt kan folatmangel føre til blodmangel (anemi) med for få røde blodceller og lavt hemoglobin, noen ganger også plager fra nervesystemet. Tilstanden kan skyldes både feil- eller underernæring, økt behov ved svangerskap og enkelte sykdommer, samt nedsatt opptak pga. sykdom.

Sist oppdatert:
22. jan. 2025
Hva er folatmangel?
Folat er vitamin B9, som kroppen trenger ved blant annet celledeling. Folsyre er en syntetisk form for folat til bruk som kosttilskudd. Befolkningsgruppene i Norge som er mest sårbare for utvikling av lave folatnivå, er gravide, eldre og personer med dårlig kosthold.
Når kroppens lagre av folat er brukt opp, begynner det å utvikle seg folatmangel. Etter hvert påvirkes kroppens evne til å danne nye røde blodlegemer. De gamle røde blodlegemene blir større. Så utvikler det seg blodmangel (anemi) med for få og for store røde blodlegemer. Denne type anemi betegnes også megaloblastanemi.
Megaloblastanemi er en sjelden årsak til anemi i Norge. Tilstanden ses for eksempel blant personer med mangelfullt kosthold (pasienter med anoreksi, alkoholikere, enkelte eldre), pasienter med nedsatt opptak av næringsstoffer i tarmen (malabsorpsjon), eller personer med visse sykdommer.
Symptomer
Folatmangel i seg selv forårsaker vanligvis få eller ingen symptomer. Symptomene skyldes først og fremst den lave blodprosenten, som vil utvikle seg dersom folatmangelen vedvarer. Denne blodmangelen (anemi) gir tretthet, svimmelhet, nedsatt fysisk yteevne, hjertebank, og tungpust, særlig ved anstrengelse. Noen ganger kan det også oppstå symptomer fra nervesystemet.
Andre tegn har sammenheng med årsaken til folatmangelen. Det er sykdommer som gir nedsatt opptak av næring i tarmen, samt feil- eller underernæring. Kronisk diaré er det mest fremtredende symptomet på sykdommer som medfører nedsatt opptak (malabsorpsjon). Slike sykdommer kan føre til nedgang i vekt, noe som også kan skyldes feil- eller underernæring.
Dersom folatmangel oppstår tidlig i graviditeten, kan den medføre alvorlige misdannelser hos fosteret, såkalte nevralrørsdefekter. For å redusere risikoen for slike komplikasjoner, er det anbefalt at alle gravide eller kvinner som ønsker å bli gravid, tar folsyretilskudd til og med den 12. svangerskapsuken. Ved økt risiko for nevralrørsdefekt hos fosteret skal den gravide ta høyere doser, se eget dokument om folat hos gravide.
Årsaker
Folat er nødvendig for dannelse av røde blodlegemer. Ved for lavt inntak eller for høyt forbruk av folat, vil det ikke kunne dannes nok røde blodlegemer. Dermed opptrer symptomer på anemi (blodmangel).
Nedsatt inntak av folat er den vanligste årsaken. Andre årsaker kan skyldes nedsatt opptak som følge av for eksempel Crohns sykdom eller cøliaki. Manglende opptak sees også som følge etter operasjon der store deler av tynntarmen er fjernet.
Personer med alkoholmisbruk har ofte et ensidig kosthold som blant annet kan føre til folatmangel. Noen legemidler kan gjøre at folat nedbrytes raskt like etter at det er inntatt. Aktuelle medikamenter er for eksempel fenytoin, trisykliske antidepressiva, p-piller, trimetoprim, metotrexat eller 5-fluouracil.
Økt behov er en sjeldnere årsak. Det kan likevel opptre under graviditet, hos for tidlig fødte barn, hos dialysepasienter, ved hemolytisk sykdom (økt skade på røde blodceller), høyt stoffskifte og ved kreftsykdom.
Diagnostikk
Sykehistorie med symptomer og tegn på blodmangel, spesielt hvis det samtidig foreligger kronisk diaré. Gulaktig og blek hud er tegn på lav blodprosent. Det kan påvises glatt og rød tunge og sår i munnvikene (såkalte ragader). Dersom det også foreligger symptomer som endringer i personens væremåte, hukommelse, eller forstyrrelser i nervesystemet, kan det foreligge samtidig mangel på vitamin B12. Måling av høyde og vekt kan bekrefte underernæring.


Blodutstryk er en nyttig prøve. Et blodutstryk lages ved at trenet helsepersonell stryker ut en dråpe blod på en glassplate. I utstryket vil legen ved mikroskopi se etter oppblåste røde blodlegemer og granulocytter (en type hvite blodlegemer) med flere kjerner enn det som er vanlig. Andre blodprøver er måling av folatnivå, som er redusert. I tillegg er det naturlig å måle nivå av vitamin B12 og ferritin, som er redusert ved jernmangel.
Behandling
Målet med behandlingen er å fylle opp igjen vitaminlagre av folat. I praksis vil dette nesten alltid medføre vitamintilskudd. Behandlingen vil vanligvis føre til bedring av en blodmangel som kan ha utviklet seg.
Hva kan du gjøre selv?
Brokkoli inneholder folat
Brokkoli inneholder folatFolat finnes særlig i dypgrønne grønnsaker, bladgrønnsaker, men også i frukt og andre næringsmidler. Den beste måten å forebygge folatmangel er å spise et variert og balansert kosthold, som er i tråd med Helsedirektoratets anbefalinger, spesielt kostrådene om frukt og grønt . Vær oppmerksom på at folat er varmeømfintlig og ødelegges lett ved oppvarming.
Hvis du er gravid eller ønsker å bli gravid, bør du ta folsyretilskudd til og med den 12. svangerskapsuken og følge kostrådene til gravide.
Medikamentell behandling
Før man begynner med behandling, er det viktig å utrede om det foreligger også andre mangeltilstand, spesielt vitamin B12-mangel. I så fall må vitamin B12-mangelen behandles først eller samtidig.
Folsyretilskudd gis daglig, vanligvis over en to- til tre måneders periode. En dosering på 0,4 - 1 mg daglig er tilstrekkelig. Ved malabsorpsjon kan det være nødvendig med opptil 5 mg daglig.
Prognose
Tilstandens forløp vil variere med grunnsykdommen. Riktig behandling fører til rask bedring av tilstanden og total korreksjon av de unormale blodverdiene oppnås i løpet av to måneder.
Dette dokumentet er basert på det profesjonelle dokumentet Folatmangel . Referanselisten for dette dokumentet vises nedenfor
- Store medisinske leksikon: folat. Britt Lande. Sist oppdatert 17.01.2020. Siden besøkt 04.07.2021 sml.snl.no
- Folatmangel. Norsk legemiddelhåndbok, T4.1.2.2. Publisert 14.06.2021. Siden besøkt 04.07.2021. www.legemiddelhandboka.no
- Austdal L, Nguyen H. Folsyre og folinsyre – hva er forskjellen? Tidsskr Nor Legeforen 2007; 127: 3284. tidsskriftet.no
- Bjørke-Monsen AL, Renstrøm R. What is optimal folate status? Tidsskr Nor Laegeforen. 2020 May 4;140(7). English, Norwegian. PMID: 32378856 PubMed
- Koury M, Wheeler AP, Sika M. Folate deficiency. BMJ Best Practice, last updated Sep 10, 2021. bestpractice.bmj.com
- Nasjonal brukerhåndbok i Medisinsk Biokjemi. Folat, P. Dato publisert: 09.03.2022. Versjon 5.3. Siden besøkt 18.7.2022. www.brukerhandboken.no
- de Benoist B. Conclusions of a WHO Technical Consultation on folate and vitamin B12 deficiencies. Food Nutr Bull. 2008 Jun;29(2 Suppl):S238-44. PMID: 18709899 PubMed
- Nordic Nutrition Recommendations 2022. NNR chapters: Public consultation. Bjørke-Monsen AL, Ueland PM: Folate. June 2022. www.helsedirektoratet.no
- Cordero AM, Crider KS, Rogers LM, Cannon MJ, Berry RJ. Optimal serum and red blood cell folate concentrations in women of reproductive age for prevention of neural tube defects: World Health Organization guidelines. MMWR Morb Mortal Wkly Rep. 2015 Apr 24;64(15):421-3. PMID: 25905896 PubMed
- Öhrvik V, Lemming EW, Nälsén C, Becker W, Ridefelt P, Lindroos AK. Dietary intake and biomarker status of folate in Swedish adults. Eur J Nutr. 2018 Mar;57(2):451-462. Epub 2016 Oct 27. PMID: 27787623 PubMed
- Koury MJ. Abnormal erythropoiesis and the pathophysiology of chronic anemia. Blood Rev 2014; 28(2): 49-66. pmid:24560123 PubMed
- Allen LH. Causes of vitamin B12 and folate deficiency. Food Nutr Bull. 2008;29(2 suppl):S20-S34.
- Ebbing M, Bønaa KH, Nygård O et al. Cancer incidence and mortality after treatment with folic acid and vitamin B12. JAMA 2009; 302: 2119 – 26. PMID: 19920236 PubMed
- Hem E. Folsyre kan øke kreftrisiko. Tidsskr Nor Legeforen 2010; 130: 711. doi:10.4045/tidsskr.10.0157 DOI
- Qin X, Cui Y, Shen L, et al. Folic acid supplementation and cancer risk: a meta-analysis of randomized controlled trials. Int J Cancer 2013 Sep; 133(5): 1033-41. pmid:23338728 PubMed
- Mortensen JH, Øyen N, Fomina T, et al. Supplemental folic acid in pregnancy and maternal cancer risk. Cancer Epidemiol 2015; 39(6): 805-11. pmid:26569032 PubMed
- Mortensen JH, Øyen N, Fomina T, et al. Supplemental folic acid in pregnancy and childhood cancer risk. Br J Cancer 2016; 114(1): 71-5. pmid:26757423 PubMed
- Svangerskapsomsorgen. Nasjonal faglig retningslinje. Sist faglig oppdatert 07.04.2021. www.helsedirektoratet.no
- Wilson RD, O'Connor DL. Guideline No. 427: Folic Acid and Multivitamin Supplementation for Prevention of Folic Acid-Sensitive Congenital Anomalies. J Obstet Gynaecol Can. 2022 Jun;44(6):707-719.e1. PMID: 35691683 PubMed
- Høyland HK, Widnes SF. Fremdeles folsyretilskudd til gravide. Norsk Farmaceutisk Tidsskrift 2010; 7-8: 19.
- TRS kompetansesenter for sjeldne diagnoser. Medisinsk informasjon om ryggmargsbrokk. Sunnaas sykehus. Publisert 12.10.2016. Sist oppdatert 07.05.2020. Siden besøkt 15.03.2022 www.sunnaas.no
- Danielsson K. et al. Nevrologiske sykdommer i svangerskapet. Norsk gynekologisk forening Veileder i fødselshjelp (2020). ePub. ISBN 978-82-692382-0-4. [hentet 15. mars 2022]. www.legeforeningen.no
- Wilson RD, Genetics Committee, Wilson Rd, et al.. Pre-conception Folic Acid and Multivitamin Supplementation for the Primary and Secondary Prevention of Neural Tube Defects and Other Folic Acid-Sensitive Congenital Anomalies. J Obstet Gynaecol Can 2015 Jun; 37(6): 534-52. pmid:26334606 PubMed